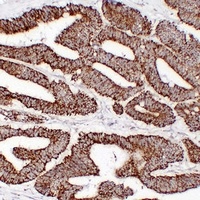
HSP60 Antibody

You have no items in your shopping cart.
- CEBPZ Rabbit Polyclonal Antibody [orb576787]
WB
Human
Canine, Equine
Rabbit
Polyclonal
Unconjugated
100 μl - HSP90 alpha Antibody [orb1474053]Featured

WB
Human, Mouse, Rat
Mouse
Monoclonal
Unconjugated
30 μl, 50 μl, 200 μl, 100 μl - HSP27 Antibody [orb216130]Featured

IF, WB
Human, Mouse, Rat
Rabbit
Polyclonal
Unconjugated
50 μl, 30 μl, 100 μl, 200 μl - HSPE1 Rabbit Polyclonal Antibody [orb101346]
IF, IHC-Fr, IHC-P
Human
Mouse, Rat
Rabbit
Polyclonal
Unconjugated
50 μl, 100 μl, 200 μl - HSP90 beta Recombinant Rabbit Monoclonal Antibody [orb2562981]
FC, ICC, IF, IHC-Fr, IHC-P, IP, WB
Human, Mouse, Rat
Human, Mouse, Rat
Rabbit
Recombinant
Unconjugated
25 μl, 100 μl, 50 μl - HSP27 Mouse Monoclonal Antibody [orb500512]
WB
Human
Mouse
Monoclonal
Unconjugated
200 μg, 200 μl, 50 μl, 100 μl - HspBP1 Rabbit Polyclonal Antibody [orb184245]
IF, IHC-Fr, IHC-P
Rat
Bovine, Canine, Equine, Human, Mouse, Porcine, Rabbit, Sheep
Rabbit
Polyclonal
Unconjugated
50 μl, 100 μl, 200 μl - DNAJA1 Rabbit Polyclonal Antibody [orb157587]
IF, IHC-Fr, IHC-P
Mouse
Bovine, Human, Porcine, Rabbit, Rat, Sheep
Rabbit
Polyclonal
Unconjugated
50 μl, 100 μl, 200 μl